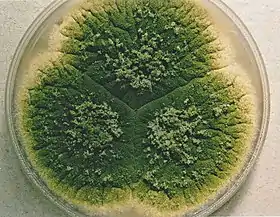

Aspergillus parasiticus
Aspergillus parasiticus é um fungo (bolor) conhecido por produzir aflatoxina,[1] embora existam estirpes que não produzem esse carcinogénico. Por vezes é encontrado em azeitonas pretas.
| Aspergillus parasiticus | |||||||||||||||
|---|---|---|---|---|---|---|---|---|---|---|---|---|---|---|---|
![]() | |||||||||||||||
| Classificação científica | |||||||||||||||
| |||||||||||||||
| Nome binomial | |||||||||||||||
| Aspergillus parasiticus Speare (1912) | |||||||||||||||
This article is issued from Wikipedia. The text is licensed under Creative Commons - Attribution - Sharealike. Additional terms may apply for the media files.